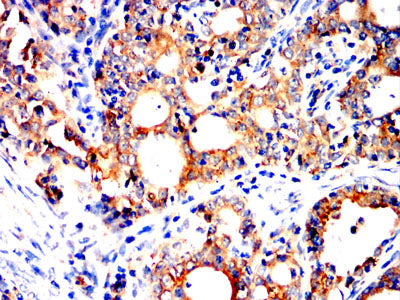

Mouse Monoclonal Antibody to P4HB
货号:
32272
别名:
DSI,GIT, PDI,PHDB, PDIA1,PO4DB, PO4HB,PROHB,CLCRP1, ERBA2L,P4Hbeta
应用:
WB,IHC,IF,FCM
反应种属:
Human
抗体类型:
Primary antibody
Swissprot:
P07237
规格:
目录价
在线咨询
Description |
|---|
This gene encodes the beta subunit of prolyl 4-hydroxylase, a highly abundant multifunctional enzyme that belongs to the protein disulfide isomerase family. When present as a tetramer consisting of two alpha and two beta subunits, this enzyme is involved in hydroxylation of prolyl residues in preprocollagen. This enzyme is also a disulfide isomerase containing two thioredoxin domains that catalyze the formation, breakage and rearrangement of disulfide bonds. Other known functions include its ability to act as a chaperone that inhibits aggregation of misfolded proteins in a concentration-dependent manner, its ability to bind thyroid hormone, its role in both the influx and efflux of S-nitrosothiol-bound nitric oxide, and its function as a subunit of the microsomal triglyceride transfer protein complex. |
References |
|---|
| 1.mBio.2020 Jan 28;11(1):e03141-19. 2.Elife.2020 May 28;9:e54612. |
Specification |
|
|---|---|
| Aliases | DSI,GIT, PDI,PHDB, PDIA1,PO4DB, PO4HB,PROHB,CLCRP1, ERBA2L,P4Hbeta |
| Entrez GeneID | 5034 |
| Swissprot | P07237 |
| clone | 4E10C6F6 |
| WB Predicted band size | 57.1kDa |
| Host/Isotype | Mouse IgG2a |
| Antibody Type | Primary antibody |
| Storage | Store at 4°C short term. Aliquot and store at -20°C long term. Avoid freeze/thaw cycles. |
| Species Reactivity | Human |
| Immunogen | Purified recombinant fragment of human P4HB (AA:309-508) expressed in mammalian. |
| Formulation | Purified antibody in PBS with 0.05% sodium azide |
Application |
|
|---|---|
| WB | 1/500 - 1/2000 |
| IHC | 1/200 - 1/1000 |
| IF | 1/200 - 1/1000 |
| FCM | 1/200 - 1/400 |
| ELISA | 1/10000 |
Product Image
-
Black line: Control Antigen (100 ng);Purple line: Antigen (10ng); Blue line: Antigen (50 ng); Red line:Antigen (100 ng)

-
Western blot analysis using P4HB mouse mAb against Hela (1), PANC-1 (2), MCF-7 (3),THP-1 (4),SW620 (5)and HepG2 (6)cell lysate.

-
Immunofluorescence analysis of Hela cells using P4HB mouse mAb (green). Blue: DRAQ5 fluorescent DNA dye. Red: Actin filaments have been labeled with Alexa Fluor- 555 phalloidin. Secondary antibody from Fisher (Cat#: 35503)

-
Flow cytometric analysis of HepG2 cells using P4HB mouse mAb (green) and negative control (red).

-
Immunohistochemical analysis of paraffin-embedded human lung cancer tissues using P4HB mouse mAb with DAB staining.

-
Immunohistochemical analysis of paraffin-embedded human cervical carcinoma tissues using P4HB mouse mAb with DAB staining.

鄂公网安备42018502007531号

